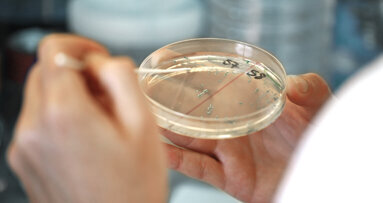
UZH: Antibiotika mit neuartiger Wirkung entdeckt

HALLE/SAALE - Neuartige bioabbaubare Stäbchen versprechen eine besser verträgliche Behandlung von Parodontitis.
Dafür haben Forscher vom Institut für Pharmazie der Martin-Luther-Universität Halle-Wittenberg (MLU) einen bereits bekannten Wirkstoff neu kombiniert und diese Erfindung zusammen mit Fraunhofer-Einrichtungen aus Halle zum Patent angemeldet. Patienten könnten damit viele Nebenwirkungen erspart werden. Die Ergebnisse dazu wurden in der Fachzeitschrift International Journal of Pharmaceutics veröffentlicht.
Parodontitis ist eine Volkskrankheit, die meist durch eine bakterielle Entzündung des Zahnfleischs ausgelöst wird. Mehr als 50 Prozent der Erwachsenen in Deutschland entwickeln im Laufe ihres Lebens eine Parodontitis, meist in höherem Alter. Mehr als zehn Millionen Deutsche haben laut Hochrechnungen eine schwere Form der Krankheit. „Durch die großen Wundflächen ist die Barrierefunktion des Körpers stark gestört, so dass vermehrt Stoffe und Bakterien in den Körper gelangen“, sagt Prof. Dr. Karsten Mäder, Leiter des Instituts für Pharmazie der MLU. Die Entzündung wirkt sich auf den ganzen Körper aus und ist oft Ursache für weitere Krankheiten wie Herzinfarkt oder Lungenentzündung. Daher ist nach mechanischen Verfahren zur Zahnreinigung oft eine Antibiotika-Gabe notwendig. Diese erfolgt normalerweise über Tabletten, wodurch der ganze Körper belastet wird. Häufige Nebenwirkungen sind Durchfall, Bauchschmerzen und Übelkeit, aber auch Hautreaktionen wie Rötungen und Juckreiz. Auch die mögliche Ausbildung von Resistenzen gegen die gängigen Antibiotika stellt bei dieser Gabe ein großes Problem dar.
Besser wäre es, das Antibiotikum würde nicht im ganzen Körper, sondern nur im Mundraum wirken. Mäders Arbeitsgruppe hat daher ein bewährtes Antibiotikum (Minocyclin) mit einem ebenso bewährten Hilfsstoff der Pharmaindustrie (Magnesiumstearat) kombiniert. „Der Komplex ist weiterhin wirksam, aber stabiler. Er setzt das Antibiotikum langsam frei, und zwar an Ort und Stelle“, erklärt Mäder. „Neben der kontinuierlichen und langanhaltenden Wirkstofffreisetzung war hierfür eine einfache Applikationsweise eine weitere Herausforderung.“ Seine Arbeitsgruppe hat auch dafür eine praktische Lösung gefunden. Sie nutzt in der Pharmazie ebenfalls bewährte Polymere. Das sind chemische Stoffe, mit deren Hilfe die Forscher biegsame, bioabbaubare Stäbchen herstellen konnten, die den Antibiotika-Komplex enthalten. Die Stäbchen können einfach in die Zahnfleischtasche geschoben werden. Da sie im Körper abgebaut werden, müssen sie im Anschluss an die Behandlung nicht wieder entfernt werden. „Die Stäbchen sind deutlich länger in vitro wirksam als bisherige Marktprodukte“, sagt Martin Kirchberg, der sich im Rahmen seiner Doktorarbeit mit dem Thema befasst. Er hat unter anderem die Zusammensetzung der Polymere optimiert, um genau die richtige Balance zwischen Festigkeit und Biegsamkeit zu erreichen und sie lange haltbar zu machen. Mittlerweile ist die Entwicklung so weit, dass eine Fertigung im großen Maßstab möglich wäre.
Das Patent für den Wirkstoffkomplex und die Formulierung wurde zusammen mit dem Fraunhofer-Institut für Zelltherapie und Immunologie IZI und dem Fraunhofer-Institut für Mikrostruktur von Werkstoffen und Systemen IMWS, beide in Halle, sowie mit den Zahnmedizinischen Kliniken der Universität Bern angemeldet. Mäder und Kirchberg sind mit je 30 Prozent an der Erfindung beteiligt, die restlichen 40 Prozent teilen sich Wissenschaftler der halleschen Fraunhofer-Institute und der Universität Bern. Eine rasche Umsetzung zunächst in klinischen Studien ist möglich, da alle Inhaltsstoffe in pharmazeutischer Qualität bereits auf dem Markt verfügbar sind. Auch die Herstellung erfolgt mit erprobten Methoden, sodass die Stäbchen schon in wenigen Jahren marktreif sein könnten. Die weitere Entwicklung der Formulierung und spätere Einführung in den Markt soll über das vom Fraunhofer IZI ausgegründete Start-Up PerioTrap Pharmaceuticals GmbH in Halle erfolgen.
Das Projekt wurde durch das Land Sachsen-Anhalt mit Mitteln aus dem Europäischen Fonds für regionale Entwicklung (EFRE) im Rahmen des „Leistungs- und Transferzentrums Chemie- und Biosystemtechnik“ finanziell unterstützt.
Schlagwörter:
ZÜRICH – Viele lebensbedrohliche Bakterien werden zunehmend resistent gegen Antibiotika. Forschende der Universität Zürich und der Polyphor AG haben ...
LEIPZIG - Mit dem Ultraschallgerät CaviTAU ist es gelungen, den bestrahlungsfreien Ultraschall auch in der Zahnmedizin anzuwenden. Im Rahmen eines ...
Nottingham – Der natürliche Zahnschmelz ist das härteste biologische Material im menschlichen Körper. Trotz seiner geringen Dicke von nur wenigen ...
DÜBENDORF - Ein biologisches Polymergerüst soll unterstützend in den Heilungsprozess eingreifen.
DRESDEN - Eine interdisziplinäre Forschungsgruppe der TU Dresden hat nach dreijähriger Arbeit das weltweit erste komplexe Verfahren entwickelt, ...
LEIPZIG – Implantate stellen momentan die komfortabelste Variante dar, um das Gebiss nach einem Zahnverlust wieder zu komplettieren. Ganz risikofrei ...
MAINZ – Wissenschaftler des Max-Planck-Instituts für Polymerforschung (MPI-P) in Mainz entwickeln derzeit Materialien, die das ...
Malmö – Menschen mit Bruxismus entwickeln eine deutlich stärkere Beißkraft als andere. Das geht aus einer schwedischen Langzeitstudie hervor, die jetzt...
Leipzig – Mit dem MIH-Symposium 2026 startet der ZWP Study Club eine neue Reihe von Online-Symposien, die aktuelle Themen aus der Zahnmedizin ...
LEIPZIG – Beruhigungssauger stimulieren den Saugreflex bei Babys – und sorgen so für Entspannung bei Mutter und Kind. Doch bei intensiver ...
Live-Webinar
Di. 23. Juni 2026
2:00 Uhr (CET) Zurich
Live-Webinar
Di. 23. Juni 2026
19:00 Uhr (CET) Zurich
Live-Webinar
Di. 23. Juni 2026
21:00 Uhr (CET) Zurich
Live-Webinar
Mi. 24. Juni 2026
14:00 Uhr (CET) Zurich
Live-Webinar
Mi. 24. Juni 2026
17:00 Uhr (CET) Zurich
Live-Webinar
Mi. 24. Juni 2026
18:30 Uhr (CET) Zurich
Dr. med. dent. Britta Hahn
Live-Webinar
Do. 25. Juni 2026
20:00 Uhr (CET) Zurich
Dr. Hatem Algraffee, Cat Edney



 Österreich / Österreich
Österreich / Österreich
 Bosnien und Herzegowina / Босна и Херцеговина
Bosnien und Herzegowina / Босна и Херцеговина
 Bulgarien / България
Bulgarien / България
 Kroatien / Hrvatska
Kroatien / Hrvatska
 Tschechien & Slowakei / Česká republika & Slovensko
Tschechien & Slowakei / Česká republika & Slovensko
 Frankreich / France
Frankreich / France
 Deutschland / Deutschland
Deutschland / Deutschland
 Griechenland / ΕΛΛΑΔΑ
Griechenland / ΕΛΛΑΔΑ
 Ungarn / Hungary
Ungarn / Hungary
 Italien / Italia
Italien / Italia
 Niederlande / Nederland
Niederlande / Nederland
 Nordic / Nordic
Nordic / Nordic
 Polen / Polska
Polen / Polska
 Portugal / Portugal
Portugal / Portugal
 Rumänien & Moldawien / România & Moldova
Rumänien & Moldawien / România & Moldova
 Slowenien / Slovenija
Slowenien / Slovenija
 Serbien & Montenegro / Србија и Црна Гора
Serbien & Montenegro / Србија и Црна Гора
 Spanien / España
Spanien / España
 Schweiz / Schweiz
Schweiz / Schweiz
 Türkei / Türkiye
Türkei / Türkiye
 Großbritannien und Irland / UK & Ireland
Großbritannien und Irland / UK & Ireland
 International / International
International / International
 Brasilien / Brasil
Brasilien / Brasil
 Kanada / Canada
Kanada / Canada
 Lateinamerika / Latinoamérica
Lateinamerika / Latinoamérica
 USA / USA
USA / USA
 China / 中国
China / 中国
 Indien / भारत गणराज्य
Indien / भारत गणराज्य
 Pakistan / Pākistān
Pakistan / Pākistān
 Vietnam / Việt Nam
Vietnam / Việt Nam
 ASEAN / ASEAN
ASEAN / ASEAN
 Israel / מְדִינַת יִשְׂרָאֵל
Israel / מְדִינַת יִשְׂרָאֵל
 Algerien, Marokko und Tunesien / الجزائر والمغرب وتونس
Algerien, Marokko und Tunesien / الجزائر والمغرب وتونس
 Naher Osten / Middle East
Naher Osten / Middle East

To post a reply please login or register